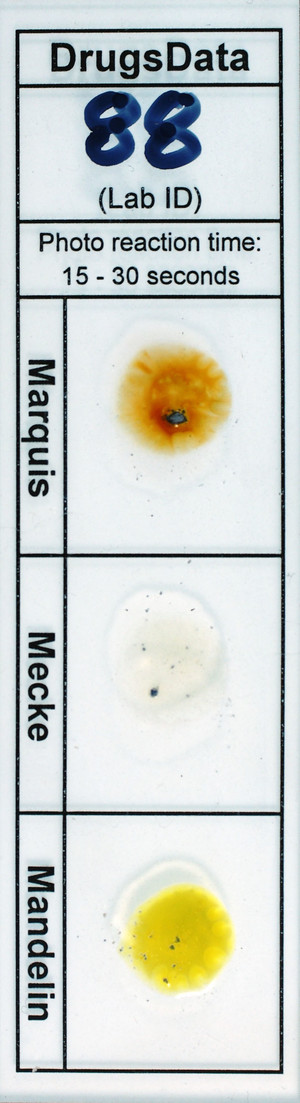
Detail Photo

New Submissions Are Not Currently Being Accepted
Samples sent after April 10, 2024 will be put on hold.
Viewing desktop version: Switch to Mobile
Philipp Plein (Skull)
Sold as: Ecstasy/MDMA
ID: 9714
Sold as: Ecstasy/MDMA
Expected to be: Cathinone or Fluoroamphetamine
Description
Blue hexagonal Philipp Plein/Skull tablet, no break line.